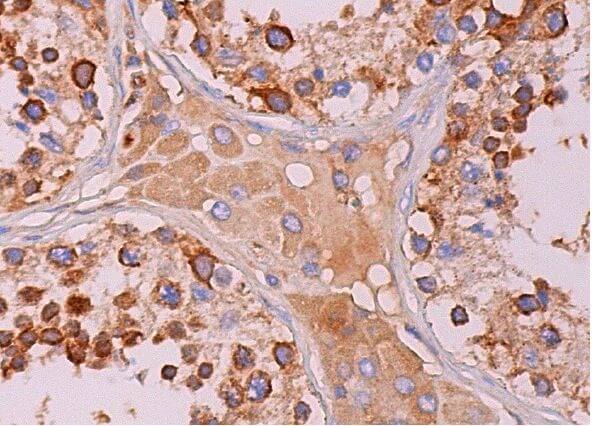
eIF3η Antibody (C-5) | SCBT - Santa Cruz Biotechnology

マイストア
変更
お店で受け取る
(送料無料)
配送する
納期目安:
2025.12.08 8:32頃のお届け予定です。
決済方法が、クレジット、代金引換の場合に限ります。その他の決済方法の場合はこちらをご確認ください。
※土・日・祝日の注文の場合や在庫状況によって、商品のお届けにお時間をいただく場合がございます。
timtum様 eIF3η Antibody (C-5) | SCBT - Santa Cruz Biotechnologyの詳細情報
eIF3η Antibody (C-5) | SCBT - Santa Cruz Biotechnology。eif3eta-antibody-c-5-western-。Puma Future z 4.1 TT - Puma White/Red Blast - Mens Cleats |。美品✨希少XLサイズ✨ユナイテッドアローズ スーツセットアップ コロンボ生地◯アイテムUNITED ARROWS ユナイテッドアローズ GREEN LABEL RELAXINGグリーンレーベルリラクシングスーツ セットアップ 上下 紺 ネイビー COLOMBO 生地 XL 50サイズメンズ◯サイズ50平置き実寸肩幅 46.5身幅 51袖丈 63(肩から) 着丈 76総丈 78.5パンツウエスト 89裾幅 19.5股上 26.5股下 79総丈 104.5◯状態AAA:全体的に大きな使用感は感じられず目立つ傷や汚れは見当たらない比較的美品で目立った汚れや傷なども感じられないためまだまだ長くご着用いただけるかと思います。神経質な方、完璧な状態をお求めの方は、ご遠慮願います。◯購入元ブランドリユース店日本流通自主管理協会加盟店(AACD)質屋・古物市場・ストア商品鑑定済み商品です。その点、ご了承ください。◯注意事項•採寸は自己採寸であり誤差が生じる可能性があること•あくまで素人検品で見落としの可能性があること古着•中古品•自宅保管であること全てご承知の上ご購入ください。(D/CNQT)【商品状態参考】SSS:新品、未使用SS:使用感がほとんど感じられない美品AAA:全体的に大きな使用感は感じられず目立つ傷や汚れは見当たらないAA: それほど気になるような目立った傷や汚れは感じられない良好品A:使用感はある古着BB少々のダメージがある古着B:シミ、汚れ等ありの古着#北の国からお届け本舗えりアパレル#北の国からお届け本舗えりメンズ。eIF3η Antibody (C-5) | SCBT - Santa Cruz Biotechnology。⚠︎あくまで中古品です。。総額40万超 ウール ビジネススーツセット ダークブルー グレー まとめ売り。ご了承の上お買い求めください。MACKINTOSH PHILOSOPHY TOROTTER セットアップ。大きいサイズ50 BEAMS F 段返り3Bセットアップスーツ グレー チェック。◯配送商品本体のみ簡易包装にて、原則1〜2日程度で発送いたしますが、仕事の都合で遅れる場合がございます。美品 ブリオーニ スーツ セットアップ ダブル ストライプ オーダーメイド。【LANVIN en Bleu】スーツ グレー ストライプ ウール 50サイズ。お急ぎの方は必ず事前にお伝えください。【美品】 スーツセレクト セットアップ M Y5 ネイビー 4S 洗える 春夏。美品3ピース✨メンズティノラス スーツ セットアップ ベージュ L。•不明な点は質問にてコメントお願い致します。美品 洗える ネイビー UNIQLO セットアップ 上下 スーツ メンズ 人気
ベストセラーランキングです
近くの売り場の商品
カスタマーレビュー
オススメ度 4.8点
現在、6688件のレビューが投稿されています。